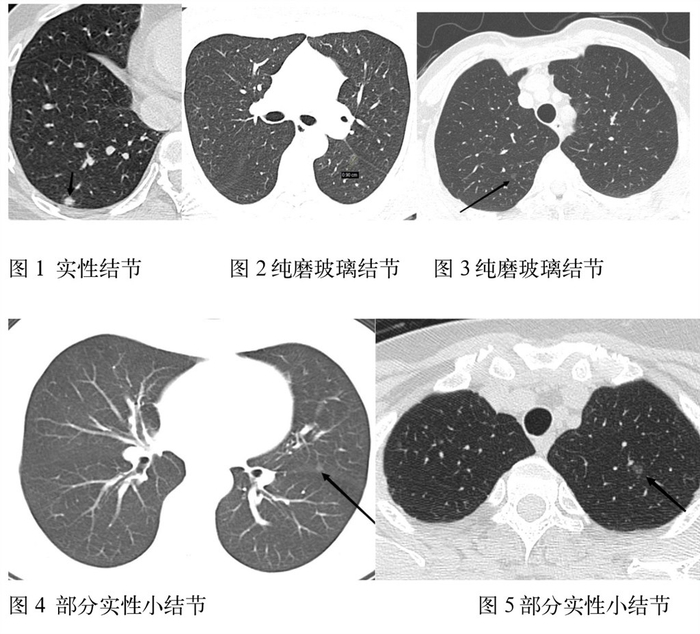

随着CT检查的普及,尤其是低剂量肺CT检查的普及,越来越多的人发现肺小结节,感觉天要塌啦,非常的焦虑,影响正常的工作和生活。
那今天我们就来聊聊肺小结节。对于我们影像科每天都会检出很多肺小结节,但超过92-95%都是良性的,即使恶性病灶绝大多数也是原位癌,只要微创切除即可,局部一般也不会复发,也不需要进一步的放化疗,大家不用太焦虑的。
每个肺结节的影像表现有以下六部分组成:首先是大小:肺窗显示平均直径6;8;15及30mm都是比较关键的数值。大小30mm,恶性概率80%以上。密度(软组织、钙化类型、脂肪);形态(实性、非实性[磨玻璃]、部分实性[包含实性和非实性成分]);位置(叶、段、具体序列和层面);边缘(平滑、分叶、毛刺);增强程度。
因此结节的评估是一个多参数的综合评价。比如:磨玻璃密度结节,边界模糊提示良性可能大,如炎性渗出或肺泡内出血等;边界清楚锐利实性结节提示良性可能;实性结节,边缘毛刺及棘状突起,提示肿瘤可能大。需要和之前的CT片进行对比,尤其是那些符合基线调查(6mm;8mm;15mm)的病例,病灶大小增加超过1.5mm视为有生长变化。恶性征象:密度不均匀,分叶,短而细密毛刺,胸膜凹陷,血管增粗、卷入、集束,淋巴结肿大,胸水,骨质破坏。增强扫描:良性病变轻-中度强化(血管瘤及硬化性血管瘤等除外),恶性病变中度以上强化。
关干结节的钙化问题,要区别对待。一般钙化结节没有明显良恶性指征。
发现肺结节,既不能掉以轻心,也不必过度惊慌。专业的事交给专业的人做。这次科普我们主要讲解大小;密度和随访三个重要指标的关系。
关于结节大小,总之但若在随访过程中,肺结节有增大趋势,尤其是成倍增长则需要考虑手术。但大家不要太紧张,这种比例相对是非常低的。
借鉴2022版的北美放射学会分级标准Lung-RADS分类用阶梯的形式给大家形象的讲解一下,随访是确定病灶升降级的主要方法。箭头方向是升降级的方向,追随观察无明显改变它也可以连降两级的呦。当然随着级别增高恶性可能性也在增加,最高级的我们影像强烈考虑恶性,稳妥的建议就切除做病理诊断。

因此肺结节的定期复查及随访非常重要,可以说变化比大小更重要。3、6、12个月还是更长时间我们医生需要根据大小,密度,两次或对比多次检查结节的变化综合考量的。3个月也不用太紧张呦,有可能医生觉得是炎性的,下次复查应该就没有啦呢!我记得刚刚上班时老主任对我说过一句话:“按周按月变化的炎症排第一,按半年、年来变化的占位排第一,数年都不变的就是疤啦,不需要理它。”总之一句话变化小的适当拉长间隔,变化大的缩短间隔时间来观察。因此第一次做胸部CT发现肺部小结节的朋友请一定不要太焦虑,更不要想着手术切除就没事啦,有没有想过结节很小绿豆黄豆大小又无变化可能就是一个疤!但如果因为它严重影响生活质量的话切除也是可以的,建议大家尽量选择微创,但损伤可能远远大于结节--高射炮打蚊子大才小用啦。
再有就是纯磨玻璃结节不要紧张,一般3omm像枣子那麽大才考虑恶性可能的!我们高度警惕应该是随访中逐渐出现了实性成分的,也就是部分实性结节直径≥8mm或实性部分12个月内平均直径增大1.5mm(体积>2mm3)逐次增加则要缩短检查间隔,需要考虑是浸润性病变,连续动态的观察至关重要,有些肺小结节就像川剧变脸一样,只是一个反派的角色扮演而已,所以表演者只是脸变,身材体型变化不大,连续的随访就能鉴别变化所以至关重要。这种明显变化的情况下建议手术切除。
随着人工智能的飞速发展和信息的互通,我们影像医生的诊断越来越依赖于人工智能软件的应用,原来依靠医生肉眼判断的事现在可以依靠软件先帮我们粗筛一遍,它的标准定得非常严苛,最大程度上避免了漏诊,再由年前医生初写一遍,上级医生审核一遍,就像给初写医生前又安排了一名不知疲倦的“小小”医生。随着医工逐渐的深入结合,这个“小小”医生拥有学习的能力越来越强,也越来越优秀,势必提高了影像诊断的准确性也的把疲劳带来的错误可能减到最低的。对于部分实性病灶中实性成分体积的改变,通过密度阈值来确定实性成分的范围再通过容积算法得到的结果是人工智能的分辨率、容积等优势的组合较医生肉眼评估差异非常明显,它是通过密度辨别、边缘勾画、计算软件的功能叠加非常精确的结果,比我们通过手动测量一个截面积乘以层数的估算结果不在一个水平上。
还有就是提醒大家肺结节的随访建议在同一就诊医院进行随访,现今CT设备最忌讳的就是每次都换一家医院做胸部CT检查。因为现在螺旋CT可以做到mm层厚,图像很多,长点的肺有300多层,打印的胶片不可能包全所有病灶,而且我们影像科可以把两次检查分屏同步显示,更有利于观察小结节的变化。因此切勿频繁更换医院就诊,这是影像医生最不愿意看到的,即使你带着很多原片,屏幕和胶片的分辨率也差好多。如果确实需要换医院请确定带好电子报告和注册挂号的智能手机,随着信息化的深入和推广,医生通过您注册的手机云胶片二维码就能看到薄层图像能比较好的比较院内外的两次影像变化,准确定级和确定合适的随访间隔时间。
作者:石洁 上海市光华中西医结合医院


